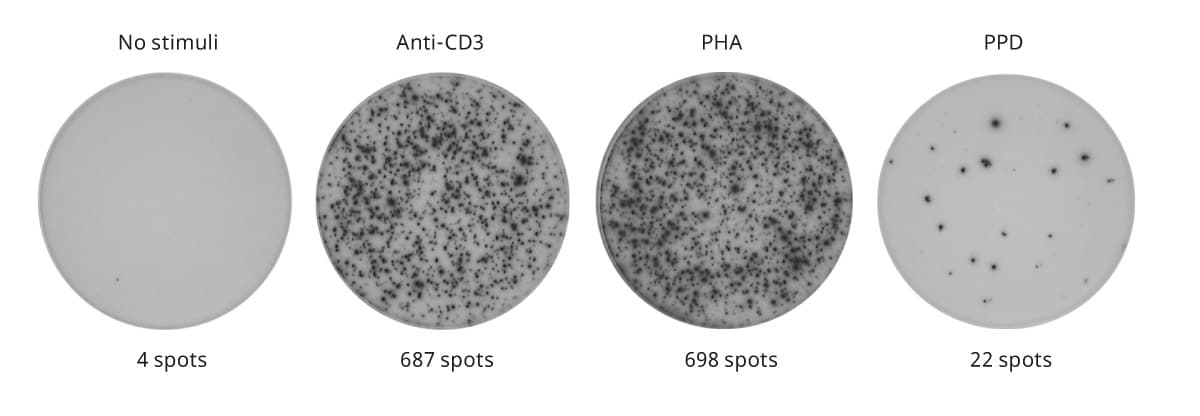

Immunoassays are our specialty at Mabtech
We run ELISpot, FluoroSpot and ELISA every day while developing new products and during our meticulous quality controls. Why not let us run your assays for you?
ELISpot and FluoroSpot are highly sensitive techniques used to analyze protein secretion by individual cells. ELISpot is recognized as the gold standard for detecting vaccine-specific responses in clinical and preclinical trials. With the added advantage of detecting multiple effector molecules simultaneously, FluoroSpot provides an even deeper insight into the functional response to a stimulus. Our team is experienced in running ELISpot and FluoroSpot assays on a daily basis, and we’re dedicated to continuously improving and developing these techniques. Trust us to handle your next ELISpot and FluoroSpot project and experience the confidence that comes with knowing your results are in capable hands.
Mabtech IRIS 2 is optimized for ELISpot and FluoroSpot.
In addition to ELISpot and FluoroSpot, we offer top-notch ELISA services for customers who want the best in precision, speed, and accuracy. Our team of highly trained experts have extensive experience in running ELISAs and use only the latest technology and best practices to deliver accurate and reliable results. Whether you’re looking to screen a large number of samples or need specific, sensitive measurements, we can help. Outsource your ELISAs to us and experience the peace of mind that comes with knowing that your results are in good hands.
T cell ELISpot: Human IFN-γ
B cell ELISpot: Human IgG and IgA
T cell FluoroSpot: Human IFN-γ, IL-2, Granzyme B
Detect pyrogens better with us
The monocyte activation test (MAT) assay is an in vitro test that is widely used to detect pyrogens in a quick, efficient, and reliable manner. Compared to the traditional in vivo rabbit pyrogen test, the MAT assay is considered to be more sensitive and specific, providing better results in less time. By outsourcing your MAT assay to us, you can take advantage of our expertise in this field, ensuring that your results are accurate and your testing process is streamlined. With Mabtech, you can feel confident in the quality of your results and the speed of your testing process.
We offer the following types of MAT assays:
- IL-6 ELISA
- IL-1β ELISA
- IL-6/IL-1β FluoroSpot
The assays are performed with pooled human PBMCs and include endotoxin or non-endotoxin pyrogens as positive controls in accordance with Eu. Pharm Chapter 2.6.30 method A, B or C.
Customer testimonials
We have used Mabtech's MAT assays for pyrogen testing of our different product batches. We are very happy with the service they have provided so far. They are fast, service-oriented, and provide a detailed report once the project is complete. We would highly recommend them to anyone who wishes to perform MAT assays.
Contact us
Send us your request below and we'll schedule a meeting to outline how to match your goals. During that first session, you'll meet one or more of our incredible service experts.